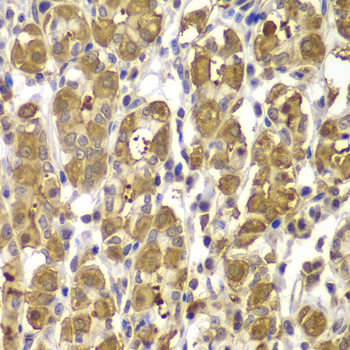

For quotations, please use our online quotation form, and you may also contact us by
service@kendallscientific.com
+1-888.733.6849 (Toll-free)
+1-617.299.7367 (Int’l))
+1-888.733.6849
Our customer service representatives are available 24 hours, Monday through Friday to assist you.| Reactivity | Human Mouse Rat |
| Tested applications | WB IHC |
| Recommended Dilution | WB 1:1000 - 1:2000 IHC 1:50 - 1:100 |
| Calculated MW | 119kDa |
| Observed MW | Refer to Figures |
| Immunogen | A synthetic peptide of human PTK2 |
| Storage Buffer | Store at -20℃. Avoid freeze / thaw cycles. Buffer: PBS with 0.02% sodium azide, 50% glycerol, pH7.3. |
| Concentration | q |
| Synonym | FADK; FAK; FAK1; pp125FAK; |

Western blot analysis of extracts of A431 cells, using PTK2 antibody.

Immunohistochemistry of paraffin-embedded rat spleen using PTK2 antibody at dilution of 1:100 (x400 lens).

Immunohistochemistry of paraffin-embedded rat heart using PTK2 antibody at dilution of 1:100 (x400 lens).

Immunohistochemistry of paraffin-embedded human kidney using PTK2 antibody at dilution of 1:100 (x400 lens).

Immunohistochemistry of paraffin-embedded human gastric cancer using PTK2 antibody at dilution of 1:100 (x400 lens).
Immunohistochemistry of paraffin-embedded human gastric injury using PTK2 antibody at dilution of 1:100 (x400 lens).

Immunohistochemistry of paraffin-embedded human esophagus using PTK2 antibody.

Immunohistochemistry of paraffin-embedded rat kidney using PTK2 antibody.
Focal adhesion kinase (FAK) is a widely expressed cytoplasmic protein tyrosine kinase involved in integrin-mediated signal transduction. It plays an important role in the control of several biological processes, including cell spreading, migration, and survival (1). Activation of FAK by integrin clustering leads to autophosphorylation at Tyr397, which is a binding site for the Src family kinases PI3K and PLCγ (2-5). Recruitment of Src family kinases results in the phosphorylation of Tyr407, Tyr576, and Tyr577 in the catalytic domain, and Tyr871 and Tyr925 in the carboxy-terminal region of FAK (6,7).
N/A